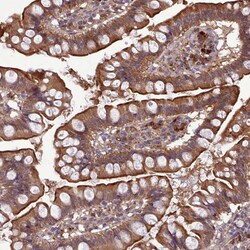
Invitrogen AHCY Polyclonal Antibody 100 &mu;L; Unconjugated:Antikörper

missing translation for 'onlineSavingsMsg'
Learn More
Learn More
Invitrogen™ AHCY Polyclonal Antibody


Rabbit Polyclonal Antibody
Marke: Invitrogen™ PA5111204
Dieser Artikel kann nicht zurückgegeben werden.
Rückgaberichtlinie anzeigen
Beschreibung
Immunogen sequence: HPSFVMSNSF TNQVMAQIEL WTHPDKYPVG VHFLPKKLDE AVAEAHLGKL NVKLTKLTEK QAQYLGMSCD GPFKPDHY Highest antigen sequence indentity to the following orthologs: Rat - 96%, Mouse - 96%.
S-adenosylhomocysteine hydrolase (AHCY) catalyzes the reversible hydrolysis of S-adenosylhomocysteine (AdoHcy) to adenosine (Ado) and L-homocysteine (Hcy). Thus, it regulates the intracellular S-adenosylhomocysteine (SAH) concentration thought to be important for transmethylation reactions. Deficiency in this protein is one of the different causes of hypermethioninemia. S-adenosylhomocysteine hydrolase belongs to the adenosylhomocysteinase family.
Spezifikation
| AHCY | |
| Polyclonal | |
| Unconjugated | |
| AHCY | |
| AA987153; Acetylation; Adenosylhomocysteinase; adoHcyase; AHCY; AL024110; cb1079; CuBP; D150; dtp; ducttrip; hm:zeh1173; hm:zeh1364; Hydrolase; Liver copper-binding protein; NAD; Polymorphism; S-adenosylhomocysteine hydrolase; S-adenosyl-L-homocysteine hydrolase; SAHH; wu:fj67b02 | |
| Rabbit | |
| Antigen affinity chromatography | |
| RUO | |
| 191 | |
| Store at 4°C short term. For long term storage, store at -20°C, avoiding freeze/thaw cycles. | |
| Liquid |
| Immunohistochemistry (Paraffin), Western Blot, Immunocytochemistry | |
| 0.1 mg/mL | |
| PBS with 40% glycerol and 0.02% sodium azide; pH 7.2 | |
| P23526 | |
| AHCY | |
| Recombinant Protein corresonding to Human AHCY. Recombinant protein control fragment (Product #RP-99353). | |
| 100 μL | |
| Primary | |
| Human | |
| Antibody | |
| IgG |
Berichtigung von Produktinhalten
Bitte geben Sie uns Ihr Feedback zu den Produktinhalten, indem Sie das folgende Formular ausfüllen.
Name des Produkts
Haben Sie Verbesserungsvorschläge?Übermitteln Sie eine inhaltliche Korrektur